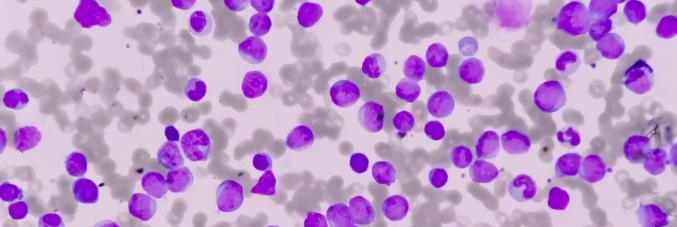
leukaemia under the microscope

Unipd Research for a New Strategy Against T-ALL Leukemia
12.02.2026
A team of researchers from the University of Padua and the Veneto Institute of Oncology (IOV–IRCCS) has identified a potential new approach to treat T-cell acute lymphoblastic leukemia (T-ALL), particularly when the disease recurs (relapse) or does not respond to standard therapies. Currently, treatment often relies on "risk-adapted" chemotherapy, which is personalized based on prognostic factors (stage, molecular markers, initial response). This method has significantly improved clinical outcomes, but a major issue remains: resistance occurs in about 20% of pediatric patients and 50% of adults with T-ALL, either in the primary tumor or during a relapse. Therefore, finding new therapeutic options is a priority.
In a recent study published in Signal Transduction and Targeted Therapy (a Nature group journal), the authors identified certain drugs capable of increasing the sensitivity of leukemic cells to venetoclax, a drug used in oncology but not very effective on its own in T-ALL.
"By blocking mTORC1, a protein complex that is excessively active in therapy-resistant leukemic cells, we observed the activation of the so-called integrated stress response, which can lead to the programmed death of cancer cells," explains Vincenzo Ciminale from the Department of Surgical, Oncological and Gastroenterological Sciences at the University of Padua, and senior author of the paper. "In this process, the BMF protein plays a crucial role, essential for triggering the death of leukemic cells. The presence of BMF could also help identify patients most likely to benefit from the combination therapy, as this protein is not expressed in all cases of T-ALL."
To test the strategy, the drug combination was evaluated in animal models: mice transplanted with leukemic cells derived from patient samples with T-ALL, then treated with different combinations or placebo.
"The efficacy of the pharmacological combination was assessed in experiments with laboratory mice, which had been transplanted with leukemic cells obtained from patient samples with T-ALL. The mice were then treated with different drug combinations or with a placebo," clarifies Loredana Urso from IOV, and first author of the article. "In animals with tumors sensitive to the treatment, a marked reduction in leukemia was observed, and importantly, with modest side effects on healthy blood cells."
In summary, the results provide a solid scientific basis for initiating future clinical studies in patients, with the aim of improving treatment for T-ALL relapses and focusing on more targeted therapies, built on the biological characteristics of the disease. The study was conducted by the University of Padua and IOV with the support of the AIRC Foundation.



